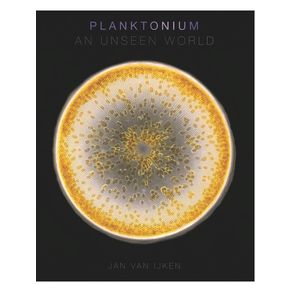
1168904.jpg 1168904.jpg

De: R$ 1.064,00Por: R$ 851,20ou X de
Economia de R$ 212,80Calcule o frete:
Para envios internacionais, simule o frete no carrinho de compras.
Calcule o valor do frete e prazo de entrega para a sua região
Sinopse
"The new book features a ton of never-before-seen photos that expose the sheer variety, wonder, and beauty of these organisms that inhabit all the waters around us." — Deeper Blue
Planktonium is a photo project and a short film by Dutch photographer/cinematographer Jan van Ijken about the unseen world of living microscopic plankton. It is a voyage into a secret universe inhabited by alien-like creatures. These stunningly beautiful, extremely diverse, and numerous organisms are unknown to most of us because they are invisible to the naked eye. However, they are wandering beneath the surface in waters all around us and are of vital importance for all life on earth. Phytoplankton (small plant-like cells) produce half of all the oxygen on earth by photosynthesis, like plants and trees do on land. Zooplankton form the base of the food chain of aquatic life. Plankton also play an important part in the global carbon cycle. They are currently threatened by climate change, global warming and the acidification of the oceans. Jan van Ijken photographed the plankton through microscopes, revealing the beauty and delicate structures of these minute organisms in the finest detail.
Ficha Técnica
Especificações
| ISBN | 9789089899293 |
|---|---|
| Subtítulo | AN UNSEEN WORLD |
| Pré venda | Não |
| Peso | 1550g |
| Autor para link | VAN IJKEN JAN |
| Livro disponível - pronta entrega | Não |
| Idioma | Inglês |
| Tipo item | LIVRO IMPORTADO ADQ MERC INTERNO |
| Número de páginas | 192 |
| Número da edição | 1ª EDIÇÃO - 2023 |
| Código Interno | 1168904 |
| Código de barras | 9789089899293 |
| Acabamento | HARDCOVER |
| Autor | VAN IJKEN, JAN |
| Editora | LANNOO PUBLISHERS * |
| Sob encomenda | Sim |